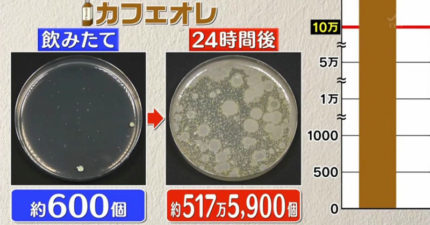

瓶裝礦泉水寫的文章


約會後被已讀不回!男寄「當晚約會明細」要求女支付 嗆走法律途徑
June 18, 2018

她回家發現「馬桶火山爆發」!浴室整間噴好噴滿 花3小時才清完
June 18, 2018

千禧世代對公司「忠誠度創新低」 萬人研究:跟薪水能力無關

接棒金曲主持!蕭敬騰「2億豪宅」意外曝光 泳池球場根本飯店等級

茱莉亞羅伯茲女兒長大了!「13歲金髮小美女」五官神似年輕翻版
飲料放隔夜「細菌量暴增500萬」 甜份越高繁衍越快!

時尚指甲無極限!最新設計「梳子美甲」 5指抓頭直接梳好梳滿

15張化腐朽為神奇「超費工電影幕後製作照」 《鐵達尼號》耗費60億台幣!

女版《瞞天過海》海倫娜曝沒參加過Met Gala 蕾哈娜嗆「因為妳穿成這樣」

影/電扶梯搭一半「天花板整片掉落」!民眾嚇壞落荒而逃 9人跑不及

過端午禁忌多!送粽子母湯「送整串」 觸犯毀你一年運勢
June 18, 2018